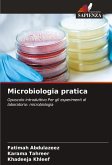
Microbiologia pratica

La batteriologia è la branca della scienza che si occupa dello studio dei batteri. Attualmente la ricerca batteriologica ha contribuito direttamente o indirettamente allo sviluppo delle biotecnologie. Concept of Practical Bacteriology è stato scritto per far capire agli studenti perché e come viene condotto ogni esperimento. Questo approccio a domande e risposte comprende tecniche e procedure ampiamente utilizzate dai ricercatori durante gli esperimenti batteriologici. Copre ricerche sull'identificazione dei batteri, la coltivazione, la crescita, il metabolismo, la genetica, la tecnologia degli enzimi, la nanobiotecnologia e altre aree fondamentali. Le caratteristiche salienti di questo libro sono la semplice descrizione delle risposte ai problemi pratici, le adeguate informazioni di base e la facile comprensione della procedura sperimentale con motivazioni importanti. Questo libro insegna ad apprendere la ricerca batteriologica in modo concettuale e a sviluppare forti capacità di pensiero. Gli studenti e i ricercatori che lavorano nel campo della batteriologia troveranno questo libro utile.
Bitte wählen Sie Ihr Anliegen aus.
Rechnungen
Retourenschein anfordern
Bestellstatus
Storno